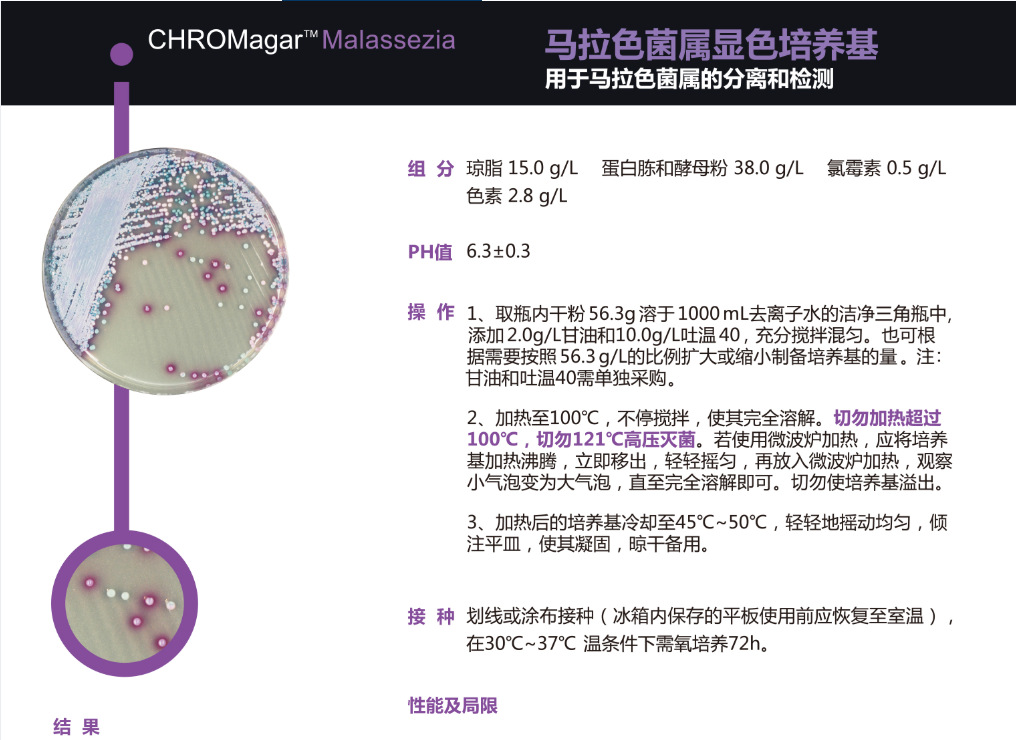
undefined

Среда для развития цвета Malachite Komajia Mz282-1, Water Dew Bio
Цена
¥1310.00 - ¥1330.00 / ≈ 15 800 ₽ – 16 041 ₽
MOQ: 2 pcs
2шт - ¥1330.00 |10шт - ¥1320.00 |30шт - ¥1310.00
Продавец
杭州水露生物科技有限公司
Рейтинг
0
Продано
0
Всего
В наличии
100
SKU суммарно
Offer ID: 999319093070
Оформить заказ
Характеристики:
| Изображение | Характеристики | Цена (CNY / RUB) | В наличии | SKU ID | Кол-во / Корзина |
|---|---|---|---|---|---|
📦 | 1L | 2шт: ¥1330.00, 10шт: ¥1320.00, 30шт: ¥1310.00 | 100 | 6149490887381 |
Статистика продавца
4.0
Сервис
Источник: API 1688
2.8
Логистика
Источник: API 1688
5.0
Споры
Источник: API 1688
5.0
Оформление
Источник: API 1688
3.0
Консультация
Источник: API 1688
0%
Повторные покупки
Источник: API 1688
5.0
Постпродажное
Источник: API 1688
Свойства товара
Модель 1 l
Происхождение /
Нужно ли импортировать No
Номер товара Mz282-1
Тип Dry powder culture medium
Класс продукта Excellent product
Содержание ≥ /
Производитель/страна происхождения Komaga
Цель For the detection of malassezia
Внедрение стандартов качества /
C.a.s Mz282-1
Бренд Komaga
Область применения For the detection of malassezia
Специальная услуга Genuine products, timely delivery, guaranteed after-sales service
Название продукта Komajia mz282-1 maraca color development medium water dew organisms
Способ оплаты Delivery upon payment
Описание товара
科玛嘉 MZ282-1 马拉色显色培养基 水露生物
货号:MZ282-1
- 规格:1L
- 产品说明:
用于马拉色菌的检测